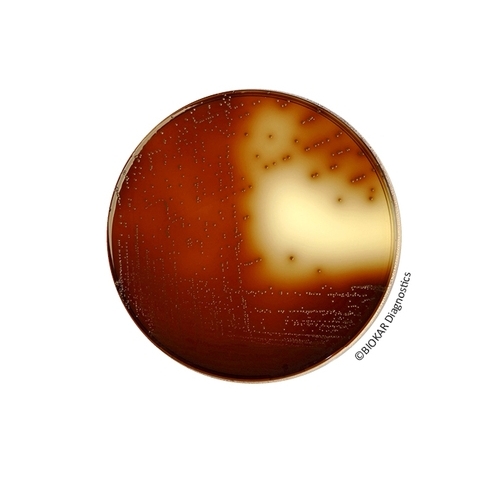
KF Streptococcus Agar (BASE)

KF Streptococcus Agar (BASE)
KF (Kenner Fecal) Streptococcus Agar is a selective medium used for the isolation and enumeration of enterococci in food products by using classic enumeration techniques on Petri plates. It is also recommended in the standard for the composition of acidifying lactic starters in dairy products, for the detection of enterococci as contaminants.
| Ürün Adı | KF Streptococcus Agar (BASE) |
| Ürün Kodu | BK132HA |
| Miktar | 500 g |
| Ürün Adı | KF Streptococcus Agar (BASE) |
| Ürün Kodu | BS02708 |
| Miktar | 10 vials |